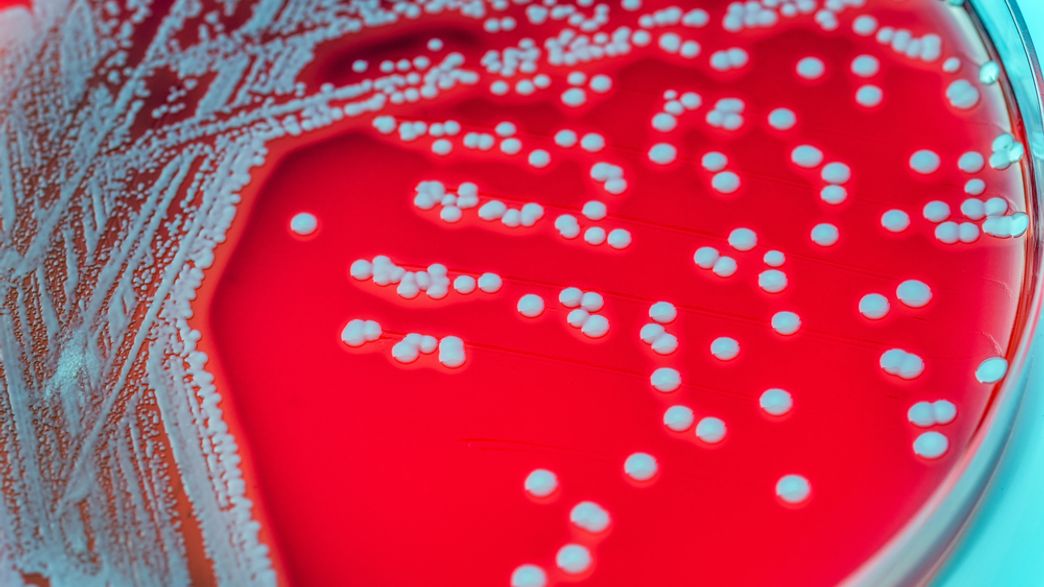

Child Cases Of Covid 19 Associated With Toxic Shock Syndrome And Rare Inflammatory Disease
Executive Summary
Looking for details on Child Cases Of Covid 19 Associated With Toxic Shock Syndrome And Rare Inflammatory Disease? You're in the right place. This collection features 7 research snippets and 8 media assets focused on Child Cases Of Covid 19 Associated With Toxic Shock Syndrome And Rare Inflammatory Disease, complemented by 3 similar topics.
People searching for "Child Cases Of Covid 19 Associated With Toxic Shock Syndrome And Rare Inflammatory Disease" are also interested in: CHILD Definition & Meaning, CDC's Developmental Milestones, Fact Sheet: CDC Childhood Immunization Recommendations.
Visual Analysis
Data Feed: 8 UnitsIntelligence Data
The United Nations Convention on the Rights of the Child defines child as, "A human being below the age of 18 years unless under the law applicable to the child, majority is attained earlier." [11]
The meaning of CHILD is a young person especially between infancy and puberty. How to use child in a sentence. Is the word kid slang?
CHILD definition: a person between birth and puberty or full growth. See examples of child used in a sentence.
CHILD definition: 1. a boy or girl from the time of birth until he or she is an adult, or a son or daughter of any…. Learn more.
1. a person between birth and full growth; a young boy or girl. 2. a son or daughter. 3. a baby or infant.
Jun 11, 2025 · Developmental Milestone Videos In this video, parents of young children share their personal experiences of using CDC’s “Learn the Signs. Act Early.” tools and resources to …
9 hours ago · For health care providers, the CDC will publish the updated Child and Adolescent Immunization Schedule by Age (through age 18) of immunization recommendations for all …
Helpful Intelligence?
Our AI expert system uses your verification to refine future results for Child Cases Of Covid 19 Associated With Toxic Shock Syndrome And Rare Inflammatory Disease.